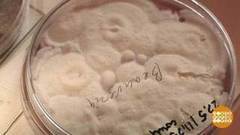
Плесени — бой! Доброе утро. Фрагмент выпуска от 10.11.2017

Плесень: обнаружить и ликвидировать! Доброе утро. Фрагмент выпуска от 22.11.2023
Зима близко — самое время вспомнить о плесени. Если дом не утеплен должным образом, плесень может поселиться на угловых соединениях. Из-за конденсата она часто образуется и по периметру окна. Соседство с ней нашему здоровью на пользу не пойдет. У разных видов плесени разные предпочтения, где расти. Белая и зеленая больше любят деревянные дома, а черная — кирпичные.
Избавиться от плесени помогут механическая сухая обработка, хлорсодержащие средства, уксус и специальные антиплесневые средства.
Разобраться в вопросе помогает микробиолог Федор Мукбенов.
Вместе с этим смотрят
529

Доброе утро
Кто живет в игрушках? Доброе утро. Фрагмент
14 713
Жить здорово!
Жить здорово! Выпуск от 19.03.2014
548

Доброе утро
Убирайся, плесень! Доброе утро. Фрагмент
1 816
Доброе утро
Плесени — бой! Доброе утро. Фрагмент выпуска от 10.11.2017


